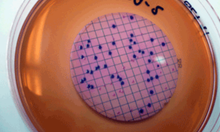
Cargar imagen en el visor de la galería, Evaluación de la Incertidumbre de Medición en Métodos de Ensayos Microbiológicos (según ISO 29201:2012)

Aunque utilizamos el dólar estadounidense (USD) como nuestra moneda de referencia, el costo que se muestra está aproximado a la moneda de su país. Es importante tener en cuenta que, al momento de efectuar el pago, puede haber pequeñas variaciones en el monto final debido a las diferencias en la cotización del tipo de cambio aplicado por su tarjeta de crédito o entidad bancaria.
Inicio: De inmediato (24 hs hábiles después de haberse acreditado el pago). O en la fecha que Ud. prefiera.
Modalidad: Autogestionado. A Distancia Asincrónica (no es necesario cumplir horarios).
Incluye consultoría permanente con el docente respecto de los temas tratados en el curso.
¿Que recibirá Ud. al finalizar el curso?
- Un certificado de aprobación o participación (dependiendo del grado de cumplimiento de los criterios para la evaluación)
- Un informe de actividades desarrolladas en la plataforma
Una vez acreditado el pago, el participante recibirá, en su casilla de email, las instrucciones necesarias para el acceso y desarrollo de los cursos en un plazo no mayor a las 24 horas hábiles (laborales).
Duración estimada: 8 semanas. Puede concluir antes dependiendo de su disponibilidad de tiempo y dedicación.
Horas certificadas: 24 (veinticuatro).
¿Que recibirá Ud. al finalizar el curso?
- Un certificado de aprobación o participación (dependiendo del grado de cumplimiento de los criterios para la evaluación)
- Un informe de actividades desarrolladas en la plataforma
Descargue desde AQUI las especificaciones del curso
Si ya ha adquirido el curso, ingrese a él desde nuestro Campus Virtual
Complete el siguiente FORMULARIO para solicitar más información o escríbanos a info@metroquimica.net
Puede comprar este curso en la presente página web o inscribirse AQUI para que nosotros iniciemos por usted el proceso de matriculación. A la brevedad le confirmaremos el pedido y le remitiremos la solicitud de pago correspondiente.
Las ofertas publicadas podrían modificarse sin previo aviso.